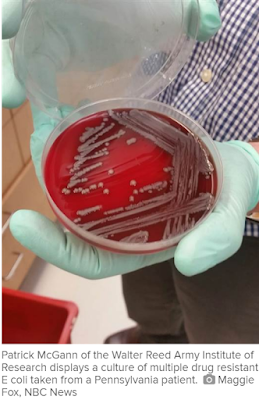

This article about the Multidrug Resistant Organism Repository and Surveillance Network (MRSN) finding the mcr-1 gene in an E. coli germ in the US should be a shot across the bow for our political leadership. For me this is another example of the need to question how we prioritize the threats not only this nation faces in the coming years, but the rest of the world as well.
The aspect of how we question is basically this: Are we balancing the allocation of limited resources properly here? Are we really that much safer purchasing, for example, another carrier battle group, or another manned fighter, or putting more money into Home Land Security for anti terrorist measures, instead of a much more robust, and integrated, bio hazard identification and rapid response force? Isn't a such a force like that just as important as the rapidly expanding cyber warfare command we're now putting together?
If we are realistic we have to accept that there will be those groups, or other national interests, which would like nothing more than to do us harm by whatever approach of force of arms they can come up with. And that is just a given we will no doubt be facing for some time to come. As such we need a seamlessly integrated military ready with state of the art capabilities with which to respond, knowing the response will require constant flexibility for changing threats, and rapidly evolving contextual situations.
The problem now is that the threats we face go far beyond just other actors on the world's geopolitical front. Ecology and biology now interact to present both clear and present dangers to our people and our physical infrastructure; threats we presently give, for the most part, short shrift to. And why is that?
Obviously resources are always finite no matter how successful your economy is, or how it is organized. As such prioritization will always be difficult because all of these threats have merit for claiming out attention. I would maintain, however, that it is precisely the way our current economic operating system is organized that not only prevents proper prioritization, but also thwarts application of resource because it is considered within the context of a cost based mind set (as opposed to an effort based mind set). A mind set where "cost" must necessarily mean a zero sum game as far as "profits" are concerned because the idea used to be that all economic entities should be subject to the levies required to pay for these answers.
It is in that type of system where rigidities become institutionalized because one entity or another gets used to producing it's profit producing answer to a threat that may, or may not, be the most pressing. Where, in fact, the whole process of deciding what is a priority becomes bogged down as various entities expend significant resource simply to sell not only their answer to a threat, but an ongoing emphasis that the threat in question is the one most deserving of further allocation.
The bottom line here is simply this: If your livelihood depends on a particular threat, and the answer to that threat that your producing entity provides, you have a built in bias that, at the very least, makes it quite difficult to be objective in decisions such as these. And it is inevitable that these biases get grafted over to the public services who we charge with the responsibility to field these answers.
The fact of the matter now is that we don't have a "seamlessly integrated military ready with state of the art capabilities with which to respond, knowing the response will require constant flexibility for changing threats, and rapidly evolving contextual situations". We have instead multiple services with overlapping redundancies that compete with each other for limited resources, even while economic entities compete with each other to build things similar to what they have always been building because that's just a great deal cheaper than completely rethinking, let alone retooling, what they do. Existing services that also make thinking outside the box on what constitutes a threat in the first place extremely difficult.
And so the responses to new biological, or ecological threats, continue to go begging, for the most part, for resources commensurate with the need these new threats ought to demand. And we are the ones made to pay, in so many ways, for the shortfall.
No comments:
Post a Comment